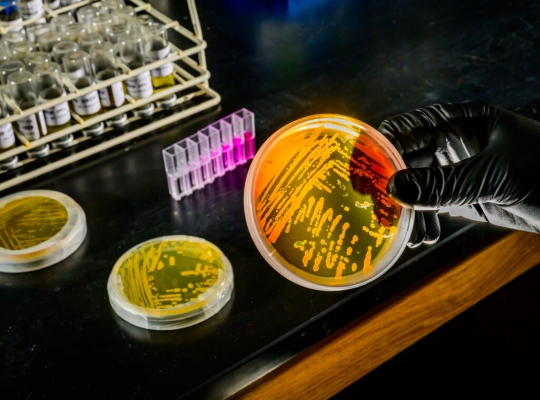

일부 해외직구 유모차와 세발자전거 등에서 납과 프탈레이트계 가소제가 검출돼 주의가 필요하다.
한국소비자원은 해외구매 유아용 삼륜차 8개 제품에 대해 8종의 유해물질, 넘어짐, 프레임 등 안전성을 평가한 결과, 일부 제품에서 국내 기준치를 넘어선 납과 프탈레이트계 가소제 등이 검출됐다고 12일 밝혔다.
키유(QIYOU)의 휴대용 접이식 분리형 휠 유모차는 손잡이에서 납이 국내 안전기준의 11배, 프탈레이트계 가소제는 무려 115배가 넘는 함량이 검출됐다. 싱하이(XINGHAI)의 스타아이 어린이 세발자전거에서는 손잡이와 벨에서 각각 안전기준의 10.7배와 2.3배의 납이 검출됐고, 손잡이에서는 프탈레이트계 가소제가 국내 기준보다 111배 많이 나왔다.
넘어질 위험도 컸다. 유아가 탑승 중 몸을 기울일 경우 사고가 발생할 수 있는 가능성을 확인한 '넘어짐(전도)' 시험에서, 키유의 유모차와 베스레이(Besrey) 유아용 세발자전거, 페이버베이비(FavorBaby) 세발자전거 등은 15° 각도 이하에서 쉽게 넘어져 국내 안전기준에 미달했다.
또 구매대행으로 판매되는 페이버베이비, 싱하이, 르코코(Lecoco) 니노S2 세발자전거, 마이두(maidou) 키즈 세발자전거 등 4개 제품 모두 안전확인신고(KC인증) 절차를 거치지 않아 '어린이제품 안전특별법'을 위반했다. 이에 소비자원은 플랫폼 사업자와 구매대행 업체들에 해당 제품의 유통과 판매를 중단하도록 권고하고, 유관기관에 위법사실을 통보했다. 업체들은 권고를 수용해 판매페이지에서 제품 삭제조치를 한 것으로 전해졌다.
발판⋅안전띠 강도, 충돌 내구성 및 직진성 등의 프레임⋅주행 안전성에서는 모든 제품이 안전기준에 적합했다.
소비자원은 유아용 삼륜차 사용 시 국내 안전기준에 적합한 제품을 구입하고 보호자와 함께 사용하며 경사로에서 사용시 주의할 것을 당부했다.
Copyright @ NEWSTREE All rights reserved.